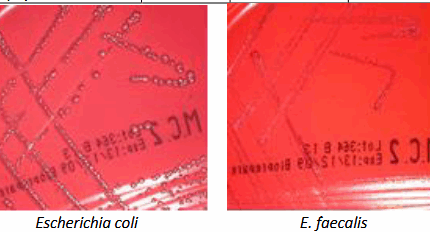

- Δίσκοι ευαισθησίας
- Προϊόντα ταυτοποίησης
- Χρωστικές
- Αναλώσιμα εργαστηρίου
- Αναλώσιμα αναλυτών
- Σωληνάρια αιμοληψιών
- Σωληνάρια αιμοληψιών κενού
- Σωληνάρια πλαστικά – πώματα
- Σύριγγες – βελόνες – πεταλούδες
- Αντικειμενοφόρες πλάκες – καλυπτρίδες – μικροαιματοκρίτες
- Πιπέτες Pasteur
- Πιπέτες Καθίζησης – Στατώ Καθίζησης
- Ρύγχη
- Τρυβλία
- Στυλεοί – κρικοφόροι
- Διαλύματα γλυκόζης
- Λάστιχο αιμοληψίας
- Παραφίλμ
- Strips
- Βαμβάκι
- Δοχεία απόρριψης βελονών
- Ουροδοχεία
- Θρεπτικά Υλικά
- Διάφορα αντιδραστήρια
BD Microlance NEEDLE 21G x 1 (100pcs)
Βελόνες μιας χρήσεως του οίκου BD™ , αποστειρωμένες σε ατομική συσκευασία.
BD Microlance NEEDLE 23G x 1 (100pcs)
Βελόνες μιας χρήσεως του οίκου BD™ , αποστειρωμένες σε ατομική συσκευασία.
BLOOD AGAR (HORSE BLOOD) BIOPREPARE Τρυβλίο 90 mm
Ένα υλικό που συνιστάται για την καλλιέργεια μιας μεγάλης ποικιλίας παθογόνων μικροοργανισμών. Τo υλικό αυτό παρασκευάζεται με την προσθήκη 5% αίματος αλόγου.
ℹ️ Ελάχιστη Παραγγελία: 10 x 90 mm
ℹ️ Συσκευασία: 10 x 90 mm
⚠️Οι τελικές τιμές επιβεβαιώνονται με την λήψη του προτιμολογίου και ενδέχεται να αλλάξουν χωρίς ειδοποίηση.
⚠️Οι φωτογραφίες έχουν αποκλειστικά ενδεικτικό χαρακτήρα & ενδέχεται να διαφέρoυν από το πραγματικό προϊόν.
BLOOD AGAR BASE BIOPREPARE Φιαλίδιο 100 ml
Το BLOOD AGAR BASE ένα υλικό που συνιστάται για την καλλιέργεια μιας μεγάλης ποικιλίας παθογόνων μικροοργανισμών. Τα υλικά αυτά συνήθως παρασκευάζονται με την προσθήκη 5 – 10% αίματος.
ℹ️ ΧΡΟΝΟΣ ΖΩΗΣ: 365 ημέρες
ℹ️ ΦΥΛΑΞΗ : 2 – 25* C
ℹ️ Ελάχιστη Παραγγελία: 10 x 100 ml
ℹ️ Συσκευασία: 10 x 100 ml
⚠️Οι τελικές τιμές επιβεβαιώνονται με την λήψη του προτιμολογίου και ενδέχεται να αλλάξουν χωρίς ειδοποίηση.
⚠️Οι φωτογραφίες έχουν αποκλειστικά ενδεικτικό χαρακτήρα & ενδέχεται να διαφέρoυν από το πραγματικό προϊόν.
BLOOD AGAR–MAC CONKEY AGAR No2 BIOPREPARE Διχοτομημένο Τρυβλίο 90 mm
Διχοτομημένο τρυβλίο BLOOD AGAR – MAC CONKEY AGAR No2 για την καλλιέργεια όλων των αερόβιων βακτηρίων και ταυτοποίηση των αιμολυτικών gram(+) κόκκων (BLOOD AGAR). – Για την καλλιέργεια , απομόνωση και ταυτοποίηση των εντεροβακτηριδίων και του εντερόκοκκου (MAC CONKEY AGAR No2).
ℹ️ Ελάχιστη Παραγγελία: 10 x 90 mm
ℹ️ Συσκευασία: 10 x 90 mm
ℹ️ ΧΡΟΝΟΣ ΖΩΗΣ: 60 ημέρες
ℹ️ ΦΥΛΑΞΗ : 2 – 8* C
⚠️Οι τελικές τιμές επιβεβαιώνονται με την λήψη του προτιμολογίου και ενδέχεται να αλλάξουν χωρίς ειδοποίηση.
⚠️Οι φωτογραφίες έχουν αποκλειστικά ενδεικτικό χαρακτήρα & ενδέχεται να διαφέρoυν από το πραγματικό προϊόν.
CHROMagar Strep A BIOPREPARE Τρυβλίο 90 mm
Το CHROMagar™ Strep Α χρησιμοποιείται για τη Ταυτοποίηση Στρεπτόκοκκων της ομάδας Α (Streptococcus pyogenes) στα φαρυγγικά δείγματα.
ℹ️ Ελάχιστη Παραγγελία: 10 x 90 mm
ℹ️ Συσκευασία: 10 x 90 mm
⚠️Οι τελικές τιμές επιβεβαιώνονται με την λήψη του προτιμολογίου και ενδέχεται να αλλάξουν χωρίς ειδοποίηση.
⚠️Οι φωτογραφίες έχουν αποκλειστικά ενδεικτικό χαρακτήρα & ενδέχεται να διαφέρoυν από το πραγματικό προϊόν.
CHROMagar Strep B BIOPREPARE Τρυβλίο 90 mm
Το CHROMagar™ Strep B χρησιμοποιείται για τη χρωματική διαφοροποίηση Streptococcus agalactiae (GBS) από το χρώμα της αποικίας.
ℹ️ Ελάχιστη Παραγγελία: 10 x 90 mm
ℹ️ Συσκευασία: 10 x 90 mm
⚠️Οι τελικές τιμές επιβεβαιώνονται με την λήψη του προτιμολογίου και ενδέχεται να αλλάξουν χωρίς ειδοποίηση.
⚠️Οι φωτογραφίες έχουν αποκλειστικά ενδεικτικό χαρακτήρα & ενδέχεται να διαφέρoυν από το πραγματικό προϊόν.
Cleanisept – 1000ml
ΦΥΣΙΚΟΘΕΡΑΠΕΙΑ, Απολύμανση - Αντισηψία, ΚΑΡΔΙΟΛΟΓΙΚΑ, Απολύμανση - Αντισηψία, ΓΥΝΑΙΚΟΛΟΓΙΚΑ, Απολύμανση – Αντισηψία, ΝΟΣΟΚΟΜΕΙΑΚΑ ΕΙΔΗ, Απολύμανση-Αντισηψία
Το Cleanisept είναι ένα συμπυκνωμένο άοσμο διάλυμα, χωρίς αιθανόλη, αλδεΰδες και φαινόλες, το οποίο μπορεί να χρησιμοποιηθεί σε καθημερινή βάση για την απολύμανση και τον καθαρισμό των δαπέδων και των επιφανειών. Μπορεί να χρησιμοποιηθεί σαν διάλυμα ταχείας απολύμανσης για επιφάνειες από ακρυλικό γυαλί.Είναι ιδανικό για χώρους εστίασης, καθώς επίσης και για χώρους αναμονής, ιατρεία κτλ.
Συμβουλευτείτε τις οδηγίες για να επιτύχετε τη σωστή αραίωση σύμφωνα με την επιθυμητή χρήση.
Περιεχόμενο: 1000ml
Τεμάχια συσκευασίας: 1
⚠️Οι τελικές τιμές επιβεβαιώνονται με την λήψη του προτιμολογίου και ενδέχεται να αλλάξουν χωρίς ειδοποίηση.
⚠️Οι φωτογραφίες έχουν αποκλειστικά ενδεικτικό χαρακτήρα & ενδέχεται να διαφέρoυν από το πραγματικό προϊόν.
Cleanisept – 5000ml
ΦΥΣΙΚΟΘΕΡΑΠΕΙΑ, Απολύμανση - Αντισηψία, ΚΑΡΔΙΟΛΟΓΙΚΑ, Απολύμανση - Αντισηψία, ΓΥΝΑΙΚΟΛΟΓΙΚΑ, Απολύμανση – Αντισηψία, ΝΟΣΟΚΟΜΕΙΑΚΑ ΕΙΔΗ, Απολύμανση-Αντισηψία
Το Cleanisept είναι ένα συμπυκνωμένο άοσμο διάλυμα, χωρίς αιθανόλη, αλδεΰδες και φαινόλες, το οποίο μπορεί να χρησιμοποιηθεί σε καθημερινή βάση για την απολύμανση και τον καθαρισμό των δαπέδων και των επιφανειών. Μπορεί να χρησιμοποιηθεί σαν διάλυμα ταχείας απολύμανσης για επιφάνειες από ακρυλικό γυαλί.Είναι ιδανικό για χώρους εστίασης, καθώς επίσης και για χώρους αναμονής, ιατρεία κτλ.
Συμβουλευτείτε τις οδηγίες για να επιτύχετε τη σωστή αραίωση σύμφωνα με την επιθυμητή χρήση.
Περιεχόμενο: 5000ml
Τεμάχια συσκευασίας: 1
⚠️Οι τελικές τιμές επιβεβαιώνονται με την λήψη του προτιμολογίου και ενδέχεται να αλλάξουν χωρίς ειδοποίηση.
⚠️Οι φωτογραφίες έχουν αποκλειστικά ενδεικτικό χαρακτήρα & ενδέχεται να διαφέρoυν από το πραγματικό προϊόν.
Cleanisept Wipes 14x20cm Dr. Schumacher GmbH
ΦΥΣΙΚΟΘΕΡΑΠΕΙΑ, Απολύμανση - Αντισηψία, ΚΑΡΔΙΟΛΟΓΙΚΑ, Απολύμανση - Αντισηψία, ΓΥΝΑΙΚΟΛΟΓΙΚΑ, Απολύμανση – Αντισηψία, ΝΟΣΟΚΟΜΕΙΑΚΑ ΕΙΔΗ, Απολύμανση-Αντισηψία
Τα Cleanisept wipes είναι μαντηλάκια έτοιμα προς χρήση, για την ταχεία απολύμανση και τον καθαρισμό των ιατρικών συσκευών και των περιοχών που βρίσκονται κοντά στον ασθενή.
Είναι ιδιαίτερα κατάλληλα για ιατρικές συσκευές που είναι ευαίσθητες στο αλκοόλ, όπως ανιχνευτές υπερήχων που δεν πρέπει να έρθουν σε επαφή με τους βλεννογόνους.
Διαστάσεις: 14cm x 20cm
Τεμάχια συσκευασίας: 1 x 100 τμχ.